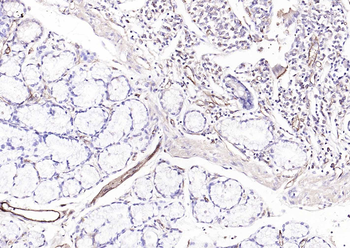
CD31 Mouse Monoclonal Antibody
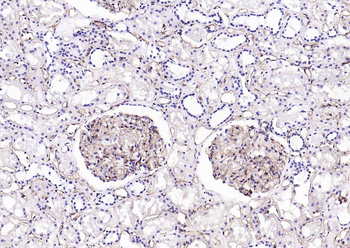
CD31 Mouse Monoclonal Antibody

You have no items in your shopping cart.
CD31 antibody
Description
Images & Validation
−| Tested Applications | ELISA, ICC, IF, IHC-P, WB |
|---|---|
| Dilution Range | WB:2 μg/ml, IHC-P:1:500, IF/ICC: 1:200 |
| Reactivity | Human, Mouse, Rat |
Key Properties
−| Host | Rabbit |
|---|---|
| Clonality | Polyclonal |
| Isotype | IgG |
| Immunogen | KLH conjugated synthetic peptide derived from human CD31. Please contact us for the exact immunogen sequence. The peptide is available as orb374712. |
| Target | CD31 |
| Molecular Weight | 82 kDa |
| Purity | Polyclonal antibodies are purified by peptide affinity chromatography |
| Conjugation | Unconjugated |
Storage & Handling
−| Storage | Maintain refrigerated at 2-8°C for up to 2 weeks. For long term storage store at -20°C in small aliquots to prevent freeze-thaw cycles. |
|---|---|
| Form/Appearance | 10 mM PBS, 0.02% sodium azide |
| Concentration | - 100 μg (in 200 μl): 0.5 mg/ml- 200 μg (in 400 μl): 0.5 mg/ml |
| Expiration Date | 12 months from date of receipt. |
| Disclaimer | For research use only |
Alternative Names
−Similar Products
−CD31 Mouse Monoclonal Antibody [orb500839]
FC, ICC, IF, IHC-Fr, IHC-P, WB
Human
Mouse
Monoclonal
Unconjugated
200 μl, 50 μl, 100 μl, 200 μgCD31/Pecam1 Rabbit Polyclonal Antibody [orb402467]
ELISA, IHC, WB
Mouse
Rabbit
Polyclonal
Unconjugated
100 μg

Quality Guarantee
Explore bioreagents carefree to elevate your research. All our products are rigorously tested for performance. If a product does not perform as described on its datasheet, our scientific support team will provide expert troubleshooting, a prompt replacement, or a refund. For full details, please see our Terms & Conditions and Buying Guide. Contact us at support@biorbyt.com.

IHC-P image of mouse kidney tissue using CD31 antibody (dilution of primary antibody at 1:500)

Immunohistochemical staining of paraffin embedded mouse skin tissue using anti-CD31 (primary antibody at 1:200)

IHC-P staining of mouse lung tissue using CD31 antibody (dilution at 1:200)

Immunohistochemical staining of paraffin embedded rat brain tissue using CD31 antibody (primary antibody at 1:100)

Immunohistochemical staining of mouse lung tissue using CD31 antibody (dilution of primary antibody - 1:200)

Western blot analysis of rat heart (lane 1), uterus (lane 2), ovary (lane 3), lung (lane4), trachea (lane 5) using CD31 antibody (primary antibody at 2 ug/ml)

Immunofluorescense analysis of mouse lung tissue using anti-CD31 (primary antibody at 1:200)

IHC-P staining of mouse lung tissue using CD31 antibody (dilution at 1:200)

IF analysis of mouse lung tissue using anti-CD31 (dilution of primary antibody at 1:200)

Immunohistochemical staining of paraffin embedded mouse skin tissue using CD31 antibody (primary antibody at 1:200)

Immunohistochemical staining of rat heart tissue using anti-CD31 (primary antibody at 1:100)

WB analysis of rat heart (lane 1), uterus (lane 2), ovary (lane 3), lung (lane4), trachea (lane 5) using CD31 antibody (dilution of primary antibody - 2 ug/ml)

IF analysis of rat kidney tissue using anti-CD31 (dilution of primary antibody at 1:100)

IHC-P image of rat skin tissue using CD31 antibody (dilution of primary antibody at 1:100)

IF analysis of rat lung tissue using anti-CD31 (dilution of primary antibody at 1:100)

IHC-P staining of rat lung tissue using anti-CD31 (dilution at 1:100)

IHC-P staining of mouse skin tissue using anti-CD31 (dilution at 1:100)

IHC-P staining of mouse kidney tissue using anti-CD31 (dilution at 1:100)

Immunofluorescence analysis of rat skin tissue using CD31 antibody (dilution of primary antibody - 1:100)

IHC-P staining of mouse skin tissue using CD31 antibody (dilution at 1:100)
Quick Database Links
Documents Download
Request a Document
Protocol Information
Filter by Applications
Filter by Species
Hideo Kagaya 1, Alexander S Kim 1, Mian Chen 1, Pei-Yu Lin 1, Xuanzhi Yin 2, Matthew Spite 2, Michael S Conte Dynamic changes in proresolving lipid mediators and their receptors following acute vascular injury in male rats Physiol Rep, (2024)
Applications
Reactivity
Geórgia da Silva Feltran 1, Rodrigo Augusto da Silva 2, Célio Junior da Costa Fernandes 1, Marcel Rodrigues Ferreira 1, Sérgio Alexandre Alcântara Dos Santos 3, Luis Antônio Justulin Junior 3, Liliana Del Valle Sosa 4, Willian Fernando Zambuzzi Vascular smooth muscle cells exhibit elevated hypoxia-inducible Factor-1α expression in human blood vessel organoids, influencing osteogenic performance Exp Cell Res, (2024)
Applications
Reactivity
Nasrin Alborzi 1, Abdulbaset Maroofi 2, Zeinab Hafizi Barjin 3, Ali Moradi 4, Mohammad Ebrahim Rezvani 3, Fatemeh Safari Resveratrol attenuates pressure overload-induced myocardial remodeling in ovariectomized rats by rescuing the adaptive angiogenic response Life Sci, (2025)
Banafsheh Heidari 1, Negar Eidi 2, Pejman Mortazavi 2, Zahra Saffarian 3, Azadeh Soltani 4, Parvin Mansouri 5, Seyed Mehdi Tabaie Morphological characteristics, mitochondrial oxidoreductase activity, and vascularization of human adipose tissues pre-and post-xenotransplantation into BALB/c female nude mice Cryobiology, (2025)
S Behzadifard, M Navaei-Nigjeh, M Behzadifard Improving Pancreatic Islet Transplantation Using Fibrin Hydrogel Containing Microvascular Fragments in Subcutaneous Tissue of Type I Diabetic Rats researchsquare.com, (2025)
Majid Zamani a , Saeid Kaviani a , Mehdi Yousefi b , Saeid Abroun a , Mohammad Hojjat-Farsangi c , Behzad Pourabbas d Conditioned plasma promotes full-thickness skin defect healing in a rat model Regenerative Therapy, (2025)
Applications
Reactivity
Jelodari, Sahar et al. Assessment of the Efficacy of an LL-37-Encapsulated Keratin Hydrogel for the Treatment of Full-Thickness Wounds ACS Appl Bio Mater, (2023)
Mai, Jingting et al. Tachycardia pacing induces myocardial neovascularization and mobilizes circulating endothelial progenitor cells partly via SDF-1 pathway in canines Heart Vessels, 31, 230-240 (2016)
Fernandez-Moure, Joseph S. et al. Cross-linking of porcine acellular dermal matrices negatively affects induced neovessel formation using platelet-rich plasma in a rat model of hernia repair Wound Repair Regen, 25, 98-108 (2017)
Valipour, Elahe et al. Anti-angiogenic effects of testis-specific gene antigen 10 on primary endothelial cells Gene, 754, 144856 (2020)
Raisi, Abbas et al. Salvia miltiorrhiza hydroalcoholic extract inhibits postoperative peritoneal adhesions in rats BMC Complement Med Ther, 21, 126 (2021)
CD31 antibody (orb10314)
Participating in our Biorbyt product reviews program enables you to support fellow scientists by sharing your firsthand experience with our products.
Login to Submit a Review